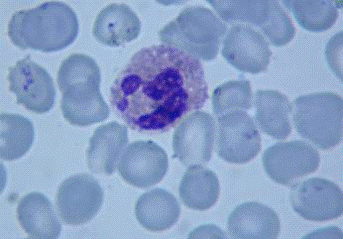
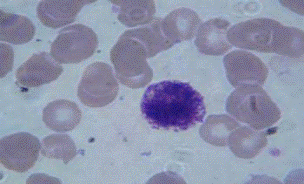
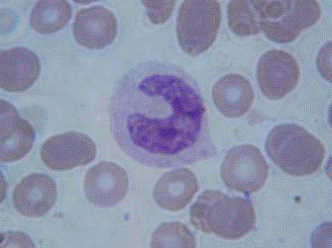
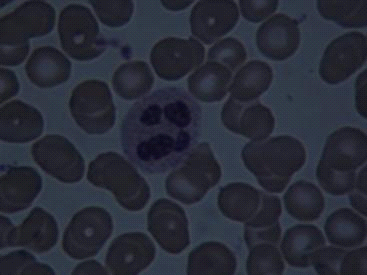

Показники гранулоцитів дітей різних вікових періодів
Зміст
Список умовних позначень
Вступ
Розділ 1. Аналітичний огляд літератури
.1 Кровотворення в онтогенезі
.1.1 Ембріональний гемоцитопоез
.1.2 Постембріональний гемоцитопоез
.2 Гранулоцитопоез
.3 Еозинофільні гранулоцити
.4 Базофільні гранулоцити
.5 Нейтрофільні гранулоцити
.6 Зміна показників лейкоцитарної формули у дітей різних вікових
груп
.7 Вікова періодизація за А.А. Маркосяном
Розділ 2. Матеріали та методи дослідження
.1 Техніка забору крові
.2 Фіксація препаратів крові
.3 Фарбування препаратів крові за Романовським-Гімзою
.4 Підрахування лейкоцитарної формули
.5 Підрахування кількості лейкоцитів
Розділ 3. Результати власних досліджень та їх обговорення
Висновки
Вступ
Актуальність. Серед сучасних проблем
однією з найважливіших є гематологічні захворювання дітей України внаслідок
Чорнобильської катастрофи. Диференційна діагностика захворювань потребує точних
показників норми крові. В сучасній гематології за останні роки виявлені нові
клітинні форми для яких вікова норма взагалі відсутня. Наприклад, вміст великих
гранулярних лімфоцитів в крові дітей та показники норми для нього сьогодні
відсутні. Відомо, що показники крові дітей, такі як гемоглобін, вміст
еритроцитів в 1 мл крові, вміст лейкоцитів у крові дітей значно відрізняються
від дорослих. Разом з тим невідомо, які клітинні форми переважають в крові в
той чи інший віковий період. Тому дослідження крові у дітей мають особливе
значення враховуючи наслідки Чорнобильської катастрофи, в результаті якої
значно збільшилася кількість онкологічних захворювань.
Кровотворення - це процес виникнення
та розвитку клітин крові. Розрізняють ембріональний гемопоез, який
розпочинається на різних стадіях ембріонального розвитку та веде до утворення
крові як тканини, і постембріональний, який можна розглядати як процес
фізіологічної регенерації крові. Число клітин крові дорослої людини відносно
постійне, не дивлячись на те, що більша кількість клітин щоденно гине.
Здійснюється це завдяки стовбуровим кровотворним клітинам, які на протязі
усього життя організму постійно поповнює промферативний пучок мієлоїдні і
лімфоїдні тканини.
В утворенні і розвитку клітин крові
важливу роль відіграє строма і мікрооточення кровотворних органів. В
ембріональному періоді кровотворення проходить на початку в жовтковому мішку,
вилочковій залозі, лімфатичних вузлах та кістковому мозку.
В постембріональний період
кровотворення здійснюється, головним чином, в кістковому мозку, селезінці,
лімфатичних вузлах. Еритроцити, гранулоцити, тромбоцити розвиваються в
червоному кістковому мозку. Згідно сучасним уявленням, в кровотворні тканини
крім морфологічно-розпізнавальних клітин, є клітини попередники різних класів.
Клітини крові поділяються на
еритроцити, лейкоцити, тромбоцити. Серед лейкоцитів виділяють агранулоцити та
гранулоцити, а агранулоцити у свою чергу поділяються на моноцити та лімфоцити.
Отже, гранулоцити - це зернисті
лейкоцити, білі кров'яні клітини, що містять в цитоплазмі специфічну
зернистість. По здатності зерен забарвлюватися гранулоцити поділяють на
еозинофіли, базофіли і нейтрофіли. У крові людини гранулоцити складають основну
масу лейкоцитів. Відсоткове співвідношення між окремими видами гранулоцитів
змінюється з віком, фізіологічним станом і при захворюваннях. Ядра гранулоцитів
поліморфні, у нейтрофілів і еозинофілів сегментовані. Зерна нейтрофілів і
базофілів безструктурні, всередині зерен еозинофілів знаходяться своєрідні
«кристали». Встановлено, що нейтрофільні зерна - це лізосоми, що містять
гідролітичні ферменти. Гранулоцити амебоїдно рухливі і здатні до фагоцитозу. З
кровоносних судин можуть проникати в сполучну тканину і брати участь в
запальних процесах.
Актуальність цієї проблеми, її
виключно важливе значення для кровотворення обумовили вибір теми дипломної
роботи « Гранулоцити крові дітей різних вікових періодів ».
Об`єктом дослідження дипломної
роботи є гранулоцити крові.
Предметом дослідження є показники
гранулоцитів дітей різних вікових періодів.
Метою дипломної роботи є з’ясувати
особливості гранулоцитопоеза у дітей різних вікових періодів.
Експериментальна база: клініко-діагностична
лабораторія при Миколаївській міській дитячій лікарні №2.
Структура роботи. Дипломна робота
складається з вступу, теоретичної частини, практичної частини, висновків,
списку використаних джерел та додатків. Загальний обсяг - … аркушів комп’ютерного
набору.
Наукова новизна дипломної роботи
полягає в тому, що на даний час відсутні показники гранулоцитів дітей різних
вікових періодів за А.А. Маркосяном.
Розділ 1. Аналітичний огляд
літератури
Кров - найважливіша інтегруюча
система, яка забезпечує обмін метаболітами і інформацією між тканинами і
клітинами [12], це основна транспортна система організму - виконує дихальну,
метаболічну, захисну функції. Маючи здатність зберігати відносну сталість свого
складу та властивостей (об’єм, кислотність, осмотичний та онкотичний тиск,
температуру, кількість форменних елементів та ін.), кров виконує функцію
стабілізації внутрішнього середовища, або гомеостазу. Крім того, кров регулює
діяльність органів і систем організму за рахунок біологічно активних речовин,
що в ній розчинені (гуморальна регуляція). До складу крові входить рідка
частина - плазма (55% об’єму) та суспензії форменних елементів: еритроцити
(червоні кров’яні тільця), лейкоцити (білі кров’яні тільця) та тромбоцити
(кров’яні пластинки). Ці форменні елементи крові, на які припадає 45% об’єму,
утворюються в кровотворних органах.
Лейкоцити відіграють важливу роль у
захисних і відновлювальних процесах організму. Їх головна функція: фагоцитоз,
утворення антитіл, руйнування і видалення токсинів білкового походження [1].
В залежності від того, містить
цитоплазма зернистість чи вона однорідна, лейкоцити поділяються на дві групи:
гранулоцити та агранулоцити.
Гранулоцити. Ці клітини складають
близько 60 % всіх лейкоцитів крові, час їх життя приблизно 2 доби. Гранулоцити,
в свою чергу, поділяються на три види. Клітини, гранули яких забарвлюються
кислими барвниками (еозином), називають еозинофілами, основними барвниками -
базофілами, нарешті, клітини, які здатні сприймати ті і інші барвники,
називають нейтрофілами. Перші забарвлюються в рожевий колір, другі - в синій,
треті - в рожево-фіолетовий [2].
Основна особливість гранулоцитів -
це наявність зернистості, яку можна поділити на дві групи: азурофільну (діаметр
гранул 0,8 мкм) і специфічну (діаметр гранул 0,5 мкм). В свою чергу специфічні
гранули можуть бути представлені в клітинах на різних стадіях розвитку:
незрілі, зрілі [5].
.1 Кровотворення в онтогенезі
Утворення клітин крові в кістковому
мозку вперше незалежно було показано Нейманном Біццоцеро у 1868 р. Опрацьований
Ерліхом метод диференційного забарвлення клітин сприяв швидкому накопиченню
знань про морфологію клітин крові. У 1898 р. Паппенгейм використав методи
забарвлення Романовського Д. Л., що дозволило йому описати перехідні форми
клітин кісткового мозку. Ці морфологічні описання лишаються класичними й на
сьогодні. Проте вивчення забарвлених клітин не давало змоги встановити їх
походження, оскільки наймолодші клітини кожної лінії були дуже схожі [10].
Кровотворенням (гемоцитопоезом)
називають процес утворення форменних елементів крові. Розрізняють: 1)
ембріональний гемоцитопоез, який призводить до розвитку крові як тканини; 2)
постембріональний гемоцитопоез, який представляє собою процес фізіологічної
регенерації крові, тобто компенсує втрату клітин у результаті їх старіння або
зруйнування. Протягом 2 - 3 місяців відновлюється весь склад крові.
Підраховано, що за сімдесят років
життя в кровотворних органах продукується близько 275 кг лімфоцитів, 460 кг
еритроцитів, 5 400 кг гранулоцитів і 40 кг тромбоцитів.
Органи, в яких відбувається
кровотворення, мають назву кровотворних. В ембріональному періоді це: жовтковий
мішок, печінка, кістковий мозок, тимус, селезінка, лімфатичні вузли. У
постембріональному періоді: червоний кістковий мозок плоских та епіфізів довгих
трубчастих кісток, селезінка, лімфатичні вузли, тимус.
1.1.1 Ембріональний гемоцитопоез
У розвитку крові як тканини можна
виділити етапи, які послідовно змінюють один одного:
• мезобластичний - розвиток клітин
крові відбувається в стінці жовткового мішка, і починається на 2 - 3 тижні
ембріонального розвитку людини. У процесі цього з’являються стовбурові
кровотворні клітини (СКК), які в подальшому диференціюються первинні клітини
крові (бласти) і дають початок первинним еритроцитам (мегалоцитам). Розвиток
еритроцитів у стінці жовткового мішка відбувається всередині первинних
кровоносних судин, тобто інтраваскулярно. Частина СКК залишається
недиференційованою і розносяться кров’ю в органи зародка, в яких розпочинається
кровотворення;
• печінковий - з 5 - 6 тижня
ембріонального розвитку і завершується перед народженням. Цей процес
відбувається в печінці, яка стає головним центром кровотворення. Тут
утворюються еритроцити, гранулоцити (в основному, нейтрофіли та еозинофіли),
мегакаріоцити. Кровотворення в печінці відбувається екстраваскулярно, вздовж
ходу кровоносних капілярів;
• наступними органами, в яких
здійснюється процес кровотворення стають тимус, селезінка та лімфатичні вузли.
У тимусі на посатку другого місяця внутрішньоутробного розвитку виникають перші
Т-лімфоцити. У селезінці на третьому місяці екстраваскулярно утворюються
еритроцити, тромбоцити та гранулоцити. Після народження в ній розвиваються лише
лімфоцити;
• кістковомозковий - починається на
другому місяці внутрішньоутробного розвитку і відбувається екстраваскулярно в
червоному кістковому мозку. Тут утворюються гранулоцити, еритроцити,
тромбоцити, моноцити та В-лімфоцити, попередники Т-лімфоцитів та природних
кіллерів. Кістковий мозок після народження стає центральним кровотворним органом,
в якому відбувається універсальний гемоцитопоез, тобто утворення всіх форменних
елементів крові.
.1.2 Постембріональний гемоцитопоез
Постембріональний гемоцитопоез
проходить мієлоїдній тканині червоного кісткового мозку і лімфоїдній тканині
селезінки, лімфатичних вузлів і тимуса. У мієлоїдній тканині відбувається
утворення еритроцитів, гранулоцитів, моноцитів і тромбоцитів, а утворення
лімфоцитів відбувається в лімфоїдній тканині.
Усі зрілі елементи крові походять з
єдиної вихідної клітини, яку називають стовбуровою кровотворною клітиною (СКК).
Стовбурова кровотворна клітина є поліпотентним попередником усіх клітин крові
(здатна диференціюватись у різних напрямках всіх видів форменних елементів
крові) і відноситься до само підтримуючої популяції клітин. У дорослих ссавців
стовбурові клітини скупчені головним чином у червомому кістковому мозку.
Виникають СКК в ембріональному періоді у жовтковому мішку і потім розселяються
по всій кровотворній системі. Їм характерні наступні властивості:
зазнають поділу протягом всього
життя організму;
диференціюються під впливом гемо
поетичних факторів;
можуть перетворюватися в будь-який
клас клітин крові.
мігрують з кісткового мозку в кров і
далі в інші кровотворні органи;
морфологічно не ідентифікуються.
Із кожної стовбурової кровотворної
клітини утворюються напівстовбурові клітини-попередники мієлопоезу або
лімфопоезу (мієлоїдна та лімфоїдна мультипотентні клітини), які мають частково
обмежені можливості, і в подальшій диференціації з них можуть утворюватися вже
не всі види форменних елементів крові. З мієлоїдної мультипотентної клітини
відбувається формування еритроцитів, гранулоцитів, моноцитів і тромбоцитів, а
утворення лімфоцитів - з лімфоїдної мультипотентної клітини. У процесі
подальшого перетворення з напівстовбурових клітин виникають уніпотентні
клітини-попередники, які можуть розвиватися лише в напрямку будь-якого
гістогенетичного ряду. Ця диференціація відбувається під впливом гемо поетичних
факторів (гемопоетинів): еритропоетинів (при утворенні еритроцитів), гранулопоетинів
(при утворенні гранулоцитів), тромбопоетинів (при утворенні тромбоцитів) та
лімфопоетинів (при утворенні лімфоцитів). Наступною стадією розвитку клітин
крові є поява клітин-попередників, які морфологічно розпізнаються в мазках
червоного кісткового мозку (бласти). У подальшому шляхом мітотичного поділу з
них виникають групи клітин, що дозрівають, які зазнають морфологічних змін і
перетворюються в зрілі форменні елементи крові.
Існують такі види гемоцитопоезу
(гістогенетичні ряди): еритропоез, гранулоцитопоез, тромбоцитопоез,
моноцитопоез, лімфопоез [23].
.2 Гранулоцитопоез
Серед гранулоцитарних клітин
розрізняють елементи трьох типів: нейтрофіли, еозинофіли і базофіли. Ранні
форми гранулоцитів є мієлобластами і складають 0,5 - 2% мієлокаріоцитів.
Мієлобласти - це клітини середнього
діаметру (10 - 15 мкм) з округлим ядром, дисперсною структурою хроматину і 2 -
3 нуклеолами. Цитоплазма їх зафарбовуїться в світло-блакитний колір.
Цитохімічно в мієлобластах нейтрофільного і еозинофільного рядів виявляються
пероксидаза, ліпіди в реакції з суданом чорним В і ШИК - позитивна речовина,
розташована в цитоплазмі дифузно. Результат цих досліджень залишається
позитивним в гранулоцитарному ряді аж до стадії сегментоядерних форм. При
ультраструктурному дослідженні в мієлобластах виявляються рибосоми, сегменти
ендоплазматичного ретикулома, гранули пероксидази в пластинчастому комплексі
(комплекс Гольджі) і ендоплазматичному ретикуломі.
Тривалість життя мієлобластів
складає 18 год. За цей час вони здатні здійснити 1 - 2 мітоза.
Н е й т р о ф і л и. про мієлоцити
нейтрофільного ряду складають 2 - 4% мієлокаріоцитів. Це великі клітини
(діаметром 13 - 18 мкм). Їх ядра розташовані ексцентрично, містять тонко
дисперсний хроматин і 1 - 2 великі нуклеоли. Цитоплазма обширна, слабо
базофільна, в ній синтезуються первинні лізосомальні гранули, які забарвлюються
азуром. Первинні гранули багаті ферментом пер оксидазою і ліпідами, які служать
цитохімічними маркерами нейтрофілів. Ці гранули зберігаються в нейтрофілах на
всьому протязі їх розвитку до зрілих форм. При ультраструктурному дослідженні
виявляється велика кількість сегментів ендоплазматичного ретикулому,
полірибосом і гранул [19, 29, 34].
Нейтрофільні мієлоцити складають 13%
мієлокаріоцитів. Їх діаметр коливається від 10 до 15 мкм. Тривалість життя
складає 104 год. Це остання стадія, на якій клітини здатні до ділення; вони
здійснюють 3 - 4 мітотичних цикли. Мієлоцити містять ядро з грубоватою
структурою хроматину і поодинокими дрібними нуклеолами. В цитоплазмі поряд з первинними,
з’являються багаточисленні вторинні гранули. Наявність останніх є специфічною
ознакою нейтрофільних мієлоцитів. Діаметр вторинних гранул складає 0,1 - 0,3
мкм, співвідношення з первинними - складає 3:1. Вони містять глікопротеїни,
лактоферин, білок, цитохроми. В них відсутні білки і ферменти, які є у
первинних гранулах. На цьому етапі в нейтрофілах з’являється лужна фосфатаза.
На більш зрілих стадіях в клітинах визначаються третинні гранули, більш дрібні,
ніж первинні і вторинні (0,1 - 0,2 мкм), близькі за складом первинним, але не
мають пероксидази. Всього із людських нейтрофілів виділено 13 фракцій гранул,
склад яких розрізняється в залежності від етапу диференціювання і
функціонального стану клітин [21, 56, 61, 62].
Метамієлоцити, паличкоядерні і
сегментоядерні нейтрофіли об’єднуються в пул клітин, нездатних до ділення. Їх
дозрівання в кістковому мозку продовжується 96 - 144 год. Протягом цього
періоду ядро клітин замість округлої набуває сегментованої форми, збільшується
ядерно-цитоплазматичне відношення. Сегментоядерні нейтрофіли затримуються в
кістковому мозку на 1 - 2 дня. За цей час їх поверхнева мембрана набуває
еластичність, яка сприяє проходженню через кістковомозковий бар’єр. Зрілі
гранулоцити кісткового мозку утворюють кістковомозковий резерв, кількість
клітин якого перевищує периферичний пул в 10 разів.
По мірі диференціювання клітин
нейтрофільного ряду змінюється їх імунофенотипична характеристика. На
поверхневих мембранах з’являється велика кількість макромолекул [35, 65].
При потраплянні в кровоносне русло
зрілі нейтрофіли або прикріплюються до судинної стінки, утворюючи пристінковий
пул, або залишаються кровотоці в якості циркулюючого пулу. Співвідношення
циркулюючого і пристінкового пулів складає в середньому 1:3. Кількість
лейкоцитів периферичної крові відображає вміст клітин циркулюючого пулу. Через
8 - 12 год. нейтрофіли проникають всередину тканин, де реалізують свої основні
функції. Вони володіють здатністю переміщатися в напрямку до вогнища інфекції,
поглинати і перетравлювати бактеріальні мікроорганізми. Складний процес
фагоцитозу є багатоетапним і включає стимуляцію визначення джерела інфекції,
хемотаксис, де грануляцію і перетравлювання мікробів. Реалізація цих процесів
відбувається за допомогою рецепторів адгезії на мембрані клітин [11, 60].
Регуляція проліферації і
диференціювання нейтропоезу здійснює комплекс гуморальних факторів. До нього
належать різноманітні види колонієстимулюючих факторів.
Поряд зі стимулюванням, відомий
також механізм інгібування розвитку гранулоцитів. Він реалізується
клітинами-супресорами.
Е о з и н о ф і л и. Еозинофільні
промієлоцити - перша морфологічно ідентифікуюча клітина еозинофільного ряду.
Вони великого розміру, мають округле ядро з тонкодисперсною структурою
хроматину. В цитоплазмі промієлоцитів виявляються первинні мономорфні округлі
гранули. Еозинофільні мієлоцити мають менший розмір і щільну структуру
хроматину ядер; їх цитоплазма містить вторинні і третинні гранули [18]. При
електронно-мікроскопічному дослідженні виявлено, що вторинні, або специфічні,
еозинофільні гранулоцити складаються із щільного ядра і матриксу. Ядро має
кристалічну структуру, містить великий базовий протеїн, катіонні білки, еозинофільно-залежний
нейротоксин, різноманітні ферменти, в гранулах матриксу визначається
пероксидаза [59]. Еозинофільна пероксидаза структурно, біохімічно та
імунологічно відрізняється від мієлопероксидази нейтрофілів, її біоактивність в
2,5 разів вища. Вона приймає участь в процесі лізису гельмінтів і зберігається
в еозинофілах при дефіциті її в нейтрофілах. Позитивна цитохімічна реакція на
пероксидазу і ліпіди зберігається в еозинофілах на всіх етапах їх
диференціювання до зрілих форм. В третинних гранулах міститься кисла фосфатаза.
По мірі дозрівання еозинофіли
проходять стадії метамієлоцитів, паличкоядерних і сегментоядерних форм. На
еозинофілах експресуються антигени, специфічні для всіх гранулоцитів.
Час дозрівання еозинофілів в
кістковому мозку складає 2 - 6 днів, циркуляції - 6 - 12 год. В периферичній
крові в нормі визначається 0,6×109/л. Фізіологічна активність еозинофілів, як і більшості
кісковомозкових клітин, залежить від впливу гуморальних регуляторів [30].
Еозинофіли виконують імунозахисну
функцію проти гельмінтної інвазії, бактерій, вірусів, грибів і, можливо, проти
пухлин. Вони є модуляторами реакції гіперчутливості. В активізованих
еозинофілах посилюється вироблення окисників, утилізація глюкози, кисню,
зменшується клітинна поверхня і щільність клітин, підвищується активність
кислої фосфатази. Еозинофіли приймають участь в регуляції системи згуртування
крові, активуючи фактор ХІІ (Хагемана) і плазміноген.
Б а з о ф і л и кісткового мозку,
крові і тучні клітини в тканинах складають загальну популяцію гістамінвмісних
елементів. Попередники базофілів КУО-Баз утворюється із КУО-ГЕММ. В кістковому
мозку і крові частина базофілів складає 0,5% ядерних клітин. У базофілів форма
ядра білобулярна. В цитоплазмі містять великі і дрібні гранули. Секретують гістамін,
кінін, специфічні естерази, трипсин і хемотрипсин [47]. Гранули базофілів
фарбуються толуїдиновим синім, альциановим синім і на відміну від нейтрофілів і
еозинофілів не містять пероксидази. В периферичній крові кількість базофілів
складає 0,2×106/л.
На поверхневій мембрані базофілів
експресується рецептор до lgE, взаємодія з яким викликає анафілактичну де
грануляцію клітин. Подібну реакцію можуть викликати також деякі лікарські
препарати, гормони, тривале охолодження. При цьому із гранул звільняється біологічно
активні речовини: гістамін і метаболіти арахідонової кислоти. Гістамін приймає
участь в негайній відповіді гіперчутливості, є потужним хемоатрактантом
еозинофілів, фіксуючи їх в місці де грануляції базофілів при астмі, алергічних
ренітах і анафілаксії. В той же час в еозинофілах містяться речовини,
інактивуючі вміст гранул базофілів [44].
Базофіли і еозинофіли є медіаторами
позаклітинного запалення, взаємодіючи з іншими компонентами імунної системи
(моноцитами, макрофагами, лімфоцитами). Вони приймають участь в нормальній
імунологічній відповіді на інфекцію, пухлину чи паразитарну інвазію. Базофіли
відрізняються від нейтрофілів і еозинофілів відсутністю здатності до фагоцитозу
[ 51].
.3 Еозинофільні гранулоцити
Еозинофіли мають округлу форму, їх розміри
перевищують розміри нейтрофілів і складають в діаметрі 12-15 мкм. Поліморфне
ядро еозинофіла займає більшу частину клітини і зазвичай складається із двох,
рідше трьох-чотирьох широких та округлих сегментів, з’єднаних перемичкою.
Цитоплазма клітини містить велику кількість великих і майже однакових за
величиною, але неоднорідних по формі зерен (гранул) - округлих, овальних або
видовжених [3].
В нормі відносний вміст
еозинофільних гранулоцитів в периферичній крові складає 1-5 % від загальної
популяції лейкоцитів, що у абсолютних одиницях відповідає 120-350 еозинофілам в
1 мкл. На кожний циркулюючий в крові еозинофіл доводиться близько 300 клітин
(зрілих та незрілих) в кістковому мозку та від 100 до 300 еозинофільних
лейкоцитів в тканинах. Тривалість життя зрілих еозинофільних гранулоцитів
складає від 3-6 год. До 3-6 діб (в середньому 48 год.), після чого клітини
підвергаються апоптозу в судинному руслі та паренхіматозних органах (легені,
печінка, селезінка).
Морфологічно еозинофільний лейкоцит
представляє собою гранулярну клітину, яка містить ексцентрично розташоване ядро
з частково стисненим хроматином та залишками нуклеол. Єдині органели, які
виявляються в еозинофілах, - апарат Гольджі та мітохондрії. Відмінною
особливістю лейкоцитів еозинофільного ряду є наявність гранул, які містять
специфічні білки, які обумовлюють їх оксифільне забарвлення.
Еозинофіли містять чотири види
секреторних гранул: кристалічні, первинні, дрібні гранули, а також секреторні
міхурці [4].
Головні функції еозинофілів - клітин
імунної системи - полягають в участі в механізмах захисту при гельмінтозах,
паразитозах і в реакціях гіперчутливості повільного типу, пов’язаних з гострою
алергією. Еозинофіли попереджують генералізацію імунної відповіді. В знищенні
антигенів (паразитів, алергенів) приймають участь різноманітні фактори,
включаючи гістамін базофілів тучних клітин. Еозинофіли контролюють надлишкове
виділення гістаміну і нейтралізують його. Вони здатні обмежити вогнище ураження
за допомогою місцевого некрозу фіброзування навколо цієї ділянки. Еозинофіли
здатні швидко проникати із судинного русла в тканини і концентруватися там у
великих кількостях у вогнищі ураження. Це призводить спочатку до
еозинофілопенії, так як еозинофіли не формують пристінковий пул, але відповідне
посилення продукції еозинофілів в кістковому мозку супроводжується
нормалізацією їх рівня в периферичній крові, а потім еозинофілією.
Факторами активації еозинофілів
служать ліпіди (лейкотрієни), пептиди, білки (імуноглобуліни, зокрема lgG),
компоненти комплементу (С3a, C5a), деякі цитокіни (ІЛ-3, ІЛ-5-і ГМ-КСФ -
колонієстимулюючий фактор для грануломоноцитопоезу). Хемотоксичними факторами
для еозинофілів, опосередкованими їх рух до місця ураження в тканинах, є
гістамін, імунні комплекси, ІЛ-8, запальний білок макрофагів.
Еозинофіли володіють цитотоксичністю
по відношенню до гельмінтів. Вони здатні сполучатися з паразитами і вводити
вміст своїх гранул в їх цитоплазму. Специфічні білки цитоплазми еозинофілів
пошкоджують личинки паразитів. При реалізації «респіраторного вибуху»
еозинофіли утворюють активні метаболіти кисню - токсичні кислі радикали.
Еозинофіли володіють здатністю до фагоцитозу і кілінгу чужорідних клітин. Вони
здатні до фагоцитозу бактерій, грибів та інших частин, здійснюючи схожий з
нейтрофілами метаболізм та механізм де грануляції, але не настільки ефективний.
Еозинофільні катіонні білки приймають участь в реакціях запалення і механізмі
згортання крові, пошкоджуючи ендотелій судин і ендокард при тривалих
гіпереозинофіліях.
Секреторна функція еозинофілів
заклечається в продукції і секреції ІЛ-2, ІЛ-3, ФІО, ІЛ-4, ІЛ-5, ІНФ-у
(гамма-інтерферон). Цитоплазматичні гранули еозинофілів секретують велику
кількість катіонних білків, ферментів, в тому числі еозинофільну
мієлопероксидазу, арилсульфатазу В, гистаминазу і фосфоліпазу D, але не
містять, на відмінну від нейтрофілів і моноцитів, лізоцим [20].
Утворення еозинофілів із
КУО-еозинофілів продовжується близько 3 - 4 діб, після чого вони протягом 2 - 5
діб залишаються в кістковому мозку. Параметри проліферації здотних до ділення
клітин еозинофільного ряду не відрізняються від від аналогічних параметрів для
нейтрофілів, але, клітини еозинофільного ряду, які не діляться в кістковому
мозку дозрівають швидше, ніж їх нейтрофільні аналоги. Час перебування на стадії
мета мієлоцита для еозинофілів складає 20 - 24 год, на стадії паличкоядерного
еозинофіла - 12 год і на стадії сегментоядерного еозинофіла - 24 год. Ростовим
фактором еозинофілів є ІЛ-5. Еозинофіли складають 0,5 - 5% всіх лейкоцитів
крові, циркулює протягом 6 - 12 год, потім потрапляють в тканини, термін їх
життя біля 12 діб. Загальна кількість еозинофілів в крові складає 2,33 - 2,91×107 клітин/кг. Тканинний
пул еозинофілів значно перевищує їх чисельність в судинному руслі. Еозинофіли в
тканинах розподілені нерівномірно. Найбільша їх кількість виявляється в
тканинах, які контактують із зовнішнім середовищем: підслизовий шар дихального,
травного і частково сечового трактів. Еозинофіли, які залишили кровоносне
русло, повторно в нього не повертаються і руйнуються шляхом апоптозу в тканинах
[7].
Для добового ритму характерна
фізіологічна мінливість кількості еозинофілів. Найбільш високі показники
спостерігаються вночі, найнижчі - вдень [11].
.4 Базофільні гранулоцити
Вміст базофілів в крові дорослих
людей складає всього лише 0 - 1%. Дозрівання базофілів в кістковому мозку
займає біля 1,5 доби. Протягом декількох діб зрілі базофіли депонуються в
синусах кісткового мозку і в периферичну кров виходять через 2 - 7 днів. В
периферичній крові базофіли циркулюють в середньому біля 6 годин.
Базофіл - клітина діаметром 8 - 10
мкм. Їх гранули дуже багаті гістаміном, мукополісахаридами, серед яких
розрізняють гепарин, гіалуронову кислоту, а також невелику кількість глікогену.
Продукція енергії в базофілах
здійснюється, головним чином, за рахунок окисного фосфорилювання, процес якого
забезпечується високим вмістом в базофілах мітохондрій і окисних ферментів.
Функції базофілів пов’язують з їх
участю в алергічних і запальних реакціях за рахунок вмісту в них біологічно
активних речовин, зокрема, гістаміну та гепарину.
Дегрануляція і звільнення гістаміну
із базофілів здійснюється під дією гуморального та клітинного факторів. В
якості гуморальних факторів виступають імуноглобуліни, зокрема імуноглобулін Е
(lg E). На мембрані базофіла є від 30 до 100 тисяч рецепторів для lg E, причому
від 10 до 40 тисяч цих рецепторів можуть фіксувати на себе lg E і визначати
пасивну сенсибілізацію організму. Процес дегрануляції базофілів може
здійснюватися і під дією інших факторів, зокрема ц-АМФ. Збільшення вмісту його
в клітині супроводжується звільненням внутрішньоклітинного гістаміну.
В сенсибілізованому організмі
дегрануляція базофілів відбувається в кровоносному руслі, в кістковому мозку,
тканинах, що визначає клініку кропивниці, свинної лихоманки та інших алергічних
захворювань. Розглядаючи значення базофілів в розвитку сенсибілізації,
необхідно відзначити їх здатність до руху, що забезпечує їх потрапляння в місця
проявлення імунологічної реакції [8].
Фізіологічне значення базофільної
клітини мало відоме. Базофільна клітина здатна фагоцитувати, але в невеликих
масштабах. Найбільш важлива подія в житті цієї клітини становить втрата
зернистості, причому це явище не локалізоване, як у інших гранулоцитів, а
спостерігається у всій клітині. З процесом втрати зернистості, в результаті
якого виділяються гепарин, гістамін і серотонін, пов’язана фізіологія і
патофізіологія базофільної клітини.
Під дією жирів крові, зокрема їх
підвищеною кількістю після їжі, базофільні клітини виділяють гепарин, який
сприяє просвітленню плазми у зв’язку з заохоченням метаболізму тригліцеридів. В
той же час, являючи собою природний антитромбінний фактор, гепарин бере участь
в гемостазі.
Значення базофільної клітини в
запальному процесі проявляється виділенням гістаміну та серотоніну, які
впливають на судини. В результаті їх впливу зростає судинна проникність,
збільшується скоротливість гладеньких м’язів. До того ж гістамін і серотонін
надають хемотоксичний вплив на еозинофіли [9].
.5 Нейтрофільні гранулоцити
Нейтрофільні гранулоцити
представляють собою найбільшу групу циркулюючх лейкоцитів. Термін
«нейтрофільний» описує зовнішній вигляд цитоплазматичних гранул при фарбуванні
по Райту - Гімзе. Разом з еозинофілами та базофілами нейтрофіли належать до
класу гранулоцитів. У зв’язку з наявністю характерного багатодолевого
(сегментованого) ядра нейтрофіли називають також поліморфно - ядерним
лейкоцитом (ПМЯЛ) [18].
Нейтрофільні лейкоцити складають
більшу частину (43 - 60% або 2,2 - 4, 2×109/л) всіх ядровмісних клітин периферичної крові.
Середній діаметр нейтрофіла 9 - 15
мкм. Зрілий нейтрофіл характеризується помірно компактним ядром паличкоподібної
або полі сегментованої форми; при полісегментації ядра зазвичай є 2 - 4
сегменти, з’єднаних перетяжками ядерної речовини. В нормі 95% нейтрофілів мають
відекс сегментації 2,44 - 3, 49 на одну клітину.
Цитоплазма фарбується в рожевий
колір, наповнена дрібною (пилеподібною) зернистістю, яка слабо сприймає азур та
еозин, тобто нейтральною; іноді при фарбуванні по Романовському зернистість має
голубовато-рожевий колір.
У 1 - 2% сегментоядерних нейтрофілів
у жінок спостерігається додатковий малий ядерний сегмент - тільце Барра або
«барабанна паличка», присутність додаткового сегменту обумовлено наявністю
другої Х - хромосоми.
При інтоксикації зернистість
цитоплазми стає більш крупною та базофільною - токсогенна зернистість.
Солітарні голубоваті включення в цитоплазмі, які спостерігаються в нейтрофілах
при скарлатині, дифтерії, важкій пневмонії, отримали назву тілець Князькова -
Делє (зараз вони спостерігаються рідко). При септичних процесах може виникати
вакуалізація цитоплазми нейтрофілів [19].
Нейтрофіли, яких ще називають
макрофагами, є головними ефекторними клітинами при гострому запаленні, першою
лінією захисту, і їх основні функції заключаються у фагоцитозі - захопленні і
перетравленні чужорідного матеріалу (мікробних агентів, грибів та інших частин)
та секреції цитокінів. Роботи І. І. Мечкнікова (1898) стали піонерними у
відкритті явища фагоцитозу, а П. Ерліх (1900) обґрунтував секреторну здатність
нейтрофілів. Враховуючи відносно обмежену тривалість їх життя, зрозуміло, що
більшість нейтрофілів повинні щоденно відновлюватись, особливо при виникненні
інфекції, коли їх кількість збільшується в 10 - 30 разів. У дорослому організмі
за 1 хвилину продукується до 120 млн нейтрофілів [20].
Для нейтрофілів характерна рухова
активність. Цьому сприяють зміни фізико-хімічних властивостей, метаболізму і
структури клітин по мірі їх дозрівання. Так, на поверхні нейтрофілів
збільшується кількість активних груп, які несуть негативний заряд, утворюється
шар, який складається із сіалових кислот, рецепторної системи, які забезпечують
хемотаксис, з’являються рецептори Fc-фрагментів lgG, компонентів комплементу та
ін. Збільшення об’єму цитоплазми, зміна її складу і фізико - хімічних
властивостей, структури ядра і інші фактори обумовлюють велику деформабільність
клітини, її рухомість.. Bessis та співавтори (1976) розрізняють наступні види
руху, які характерні для нормальних нейтрофілів: 1) внутрішньоклітинний - текучість
цитоплазми або циклоз, осциляція центросом, ротація ядра, обертання клітини
навколо центросоми, скоротливі вакуолі; 2) рух клітинної поверхні (безперервне,
хвилеподібне); 3) цитоплазматична експансія - утворення різного походження
виростів, псевдоподій; 4) раптове роз пластування на поверхні; 5) хемотаксис;
6) адгезивність до клітин, різноманітних частин та ін., яка тісно пов’язана з
фагоцитарною активністю лейкоцитів; 7) рух, пов'язаний з ендоцитозом та
екзоцитозом.
Ендоцитоз - це проникнення в клітину
різноманітних субстанцій, що забезпечується активною діяльністю клітини завдяки
утворенню псевдоподій, інвагінацій і травних вакуолей. До ендоцитозу належить
фагоцитоз, піноцитоз, рофеоцитоз. Екзоцитоз, навпаки, це виділення в оточуюче
клітину середовище різноманітних субстанцій (наприклад, продуктів фагоцитозу),
яке відбувається шляхом або секреції, або клазматозу. Всі ці види клітинного
руху мають суттєве значення в фагоцитозі.
Різноманітні функціональні
властивості нейтрофілів, їх рухова властивість, швидкість зміни руху, адгезія
та інші змінюються по мірі дозрівання клітин. Так, в більш зрілих клітинних
елементів на відміну від менш зрілих кількість клітин, які володіють адгезивною
здатністю до скла, збільшується; якщо серед мієлобластів адгезивні властивості
спостерігаються лише у 2% клітин, то серед мета мієлоцитів - у 57%, а серед
сегментоядерних нейтрофілів - у 90%. Броунівський рух цитоплазми, який
з’являється в мієлоцитах, також посилюється по мірі дозрівання клітин. Але цей
тип руху властивий приблизно тільки 80% клітинчим більш зрілою стає клітина
нейтрофільного ряду, тим більшою здатністю вона володіє до розпластування,
цитоплазматичної експансії, міграції. Якщо швидкість руху метамієлоцита складає
3 - 7 мкм/хв., то у сегментоядерного нейтрофіла вона, як правило, в 4 - 7 разів
вища (28 мкм/хв.). Саме завдяки здатності лейкоцитів до руху забезпечується ряд
їх функцій, зокрема фагоцитоз.
Фагоцитарна активність є основною
функцією нейтрофілів. Вона мінімально виражена в мієлоцитах різко збільшена в більш
зрілих. Процес протимікробного захисту нейтрофілами складається із ряду
послідовних етапів, які включають в себе розпізнавання мікробу, ціленаправлене
переміщення до нього (хемотаксис), опсонізацію і власне фагоцитоз з подальшим
перетравлюванням мікробу.
При появі об’єкту фагоцитозу
нейтрофіли орієнтують свій рух в цьому напрямку. Цей ціленаправлений рух клітин
із судинного русла в тканину викликається хемотаксичними факторами, воно
супроводжується змінами будови мембрани та внутрішньої структури нейтрофілів.
Хемотаксичними властивостями
володіють ряд сполук, що виділяють бактерії і мають різноманітну молекулярну
масу; речовини з низькою молекулярною масою діють безпосередньо на нейтрофіли,
тоді як з високою - виявляють свій вплив лише в присутності сивороткових
білків. До числа хемотаксичних факторів належать також компоненти системи
комплементу С3 і С5, протеази нейтрофілів і тканин, фібринопептид В, фрагменти
колагену, циклічні пуринуклеотиди, муко
полісахариди, продукти
антигенстимулірованих лімфоцитів та ін. Під впливом хемотаксичних факторів
лейкоцит набуває трикутну форму - загострений виріст (протопод) направлений в
сторону руху клітини, і нейтрофіл переміщується. Останнє забезпечується актин-
та міозинконтрактильними білками.
Поряд з появою хемотаксичних
факторів може розвиватись феномен так званої хемотаксичної дезактивації. В
цьому випадку лейкоцити втрачають здатність до хемотаксису. Ці фактори можуть
бути: а) неспецифічними, коли знижується реакція клітини на хемотаксичні
фактори будь-якого походження; б) специфічними, коли реакція знижується тільки
на деякі дезактивуючі субстанції.
Хемотаксична активність нейтрофілів
у дітей різного віку відрізняється від дорослих. У недоношених дітей з малою
масою тіла при народженні 800 - 1400 г) вона значно знижена, особливо в перші
два тижні після народження. Хемотаксична активність у доношених новонароджених
дітей також знижена; з віком вона збільшується, досягаючи рівня дорослих до 2 -
5 річного віку.
Після наближення до об’єкта
фагоцитозу настає друга фаза - реакція опсонізації, тобто фіксація фагоцитуючих
речовин на поверхні клітин, і безпосередньо з нею пов’язана реакція поглинання.
В процесі опсонізації спостерігають ряд змін, які роблять об’єкт фагоцитозу
більш «поглинаючо-здатним». Так, на поверхні нейтрофілів, направленої в сторони
об’єкту фагоцитозу, формується ділянка з пластинчастою будовою мембрани. На ній
концентрується велика кількість рецепторів, які беруть участь у фагоцитозі.
Одночасно відбувається де грануляція нейтрофілів, звільняються додаткові
рецепторні і окисні компоненти. Процес опсонізації залежить як від
гранулоцитів, так і від позаклітинних факторів. перш ніж поглинаючий субстрат
фіксується на поверхні клітини, він з’єднується з опнінами.
Об’єкт фагоцитозу, фіксований до
мембрани гранулоцита, оточується псевдоподіями, які захоплюють його, і
утворюється фагоцитарна вакуоля (фагосома). Слідом за поглинанням відбувається
злиття фагосоми з азурофільними гранулами з подальшим їх руйнуванням. Останнє
протікає протягом 0,2 - 0,3 с. В результаті де грануляції нейтрофілів
викидається вміст гранул. Таким чином, об’єкт фагоцитозу виявляється в
середовищі з високим вмістом кислих і нейтральних протеаз, гідролаз, а також
інших активних ферментних систем. Це призводить до «вбивства» бактерій, їх руйнування
з подальшим екзоцитозом.
Процес фагоцитозу протікає зі
значними біохімічними зрушеннями в нейтрофілах. Бактерицидна система
нейтрофілів може бути кисневозалежною і кисневонезалежною. При першій різко
збільшується споживання О2, іноді в 50 разів у порівнянні з вихідними даними.
Кисневонезалежна бактерицидна
система забезпечується за рахунок бактерицидної дії катіонітного білка, який
активний тільки у відношенні грам негативних мікробів. Дія білка основана на
збільшенні проникності мембрани бактерій для різноманітних гідрофобних молекул.
Після «вбивства» мікробів
відбувається їх повне руйнування під дією різноманітних протеаз і ліпаз, а
потім екзоцитоз. З моменту поглинання мікробів клітина змінює форму, стає
малорухомою, і при ефективному фагоцитозі сегментоядерний нейтрофіл гине.
Поглинаюча здатність нейтрофілів у
дітей в період новонародженості і в наступні періоди дитинства суттєво не
відрізняється від дорослих. Але протягом перших 6 місяців життя дитини
показники завершеного фагоцитозу відносно низькі. У недоношених дітей
відмічається зниження фагоцитарної і бактерицидної функцій нейтрофілів.
Зниження бактерицидної функції пов’язано з меншою активністю ферментних систем,
зменшенням вмісту неферментних катіонітних білків.
Але функція нейтрофілів не
обмежується тільки фагоцитозом. Вони здатні виділяти в оточуюче їх середовище
лізосомальні ферменти, піроген, містять речовини, які впливають на процес
згуртування крові, беруть участь в первинному гемостазі, впливають на
реологічні властивості крові [21].
Але показники лімфоцитів,
еозинофілів, базофілів на сьогоднішній день не вивчались.
гранулоцит гемоцитопоез лейкоцит
1.6 Зміна показників лейкоцитарної
формули у дітей різних вікових груп
В периферичній крові в перші дні
життя після народження кількість лейкоцитів до 5-го дня життя перевищує 18 - 20×109/л, причому
нейтрофіли складають 60 - 70% всіх клітин білої крові.
Лейкоцитарна формула зрушена вліво
за рахунок високого вмісту паличкоядерних і в меншій мірі метамієлоцитів
(юних). Можуть виявлятися і поодинокі мієлоцити.
Значні зміни перетерпає лейкоцитарна
формула, що виражається в зменшенні кількості нейтрофілів і збільшенні
кількості лімфоцитів.
На 5-й день життя їх кількість
порівнюється (так званий перший перехрест), складаючи близько 40 - 44% у формулі
білої крові. Потім відбувається подальше зростання кількості лімфоцитів (до
10-го дня до 55 - 60%) на тлі зниження кількості нейтрофілів (приблизно 30%).
Поступово зникає зсув формули крові
вліво. При цьому з крові повністю зникають мієлоцити, зменшується кількість
метамієлоцитів до 1% та паличкоядерних - до 3%.
Наступні тижні, місяці та роки життя
у дітей зберігається ряд особливостей кровотворення, а баланс утворення,
дозрівання кров’яних клітин і їх споживання і руйнування визначають склад
периферичної крові дітей різного віку.
В процесі росту дитини найбільші
зміни перетерпає лейкоцитарна формула, причому серед форменних елементів
особливо значні зміни кількості нейтрофілів та лімфоцитів.
Після року знову збільшується
кількість нейтрофілів, а кількість лімфоцитів поступово знижується.
У віці 4 - 5 років знову
відбувається перехрест в лейкоцитарній формулі, коли кількість нейтрофілів і
лімфоцитів знову зрівнюється.
В подальшому спостерігається
зростання кількості нейтрофілів при зниженні кількості лімфоцитів.
З 12 років лейкоцитарна формула уже
мало чим відрізняється від дорослої людини. Поряд з відносним вмістом клітин,
що входять у визначення «лейкоцитарна формула», цікавість представляє
абсолютний їх вміст в крові.
Абсолютна кількість нейтрофілів найбільша
у новонароджених, на першому році життя їх кількість стає найменшою, а потім
знову зростає, перевищуючи 4×109/л в периферичній крові [13, 14, 15, 16].
Окремі органи й системи дозрівають
поступово й завершують свій розвиток у різні періоди життя. Це зумовлено
особливостями функціонування дитячого організму. Основними етапами розвитку є
ембріональний (внутрішньоутробний) та постнатальний (починається з моменту
народження). В ембріональний період закладаються всі органи, тканини,
відбувається їх диференціювання. У постнатальний період (період дитинства)
продовжують розвиватися органи й системи, відбувається якісна перебудова
функцій організму. Для кращого розуміння та систематизації цих процесів
розроблені різні варіанти періодизації розвитку дитини. Одна із них, в основі
якої лежать морфофункціональні й психологічні критерії (за А.А. Маркосяном)
наведена нижче:
Новонароджений (1-10 днів);
Грудний період (10 днів - 1 рік);
Раннє дитинство (1-3 роки);
Перше дитинство (4-7 років);
Друге дитинство (8-12 років -
хлопчики, 8-11 років - дівчатка);
Підлітковий період (13-16 років -
хлопчики, 12-15 років дівчатка);
Юнацький період (17-21 рік - юнаки,
16-20 років - дівчата) [26].
У новонародженої дитини виникають різні
пристосовані рефлекторні реакції до нових умов життя - самостійне дихання і
кровообіг, харчування. Починають самостійно працювати легені, серце, печінка та
нирки. Кістки новонародженої дитини містять мало мінеральних солей, тому вони
дуже м’які й легко викривляються за неправильного догляду. Кістки черепа також
м’які, ще не зрощені по швах. У місцях з’єднання 3 - 4 кісток є так звані
тім’ячка, що до 10 - 12 місяців мають закритися. Рухи безладні, голівку дитина
самостійно тримати не може. У новонародженої дитини підвищений обмін речовин,
частота дихання становить 40 - 60 дихальних рухів за 1 хв. (для порівняння: у
дорослої людини - 16 - 18 дихальних рухів за 1 хв.), а серцевих скорочень - 120
140 ударів за 1 хв. (для порівняння: у дорослої людини - 60 - 70 ударів за 1
хв.). Травна система, зокрема її залози, недорозвинена, тому найменші порушення
у голодуванні або питному режимі можуть спричинити тяжкі розлади травлення.
Нервова система також недорозвинена. Більшу частину доби дитина спить і
прокидається тільки від голоду або неприємних відчуттів - холоду від мокрих
пелюшок, болю у животику. Новонароджена дитина зовсім безпорадна і повністю
залежна від піклування батьків. Опірність новонародженого організму впливам
зовнішнього середовища дуже низька, тому дитина легко піддається захворюванням.
У грудний період дитина розвивається
дуже швидкими темпами. За рік довжина її тіла у середньому збільшується на 25
см. Маса здорової дитини до четвертого місяця подвоюється, а до року -
потроюється. Швидко розвивається опорно - руховий апарат. У два місяці дитина
вже може на 1 - 2 хв. підняти голівку, у чотири - перевернутися зі спини на
живіт. У шість місяців вона може самостійно сидіти, у сім - повзати, у вісім -
тримаючись за перекладинку ліжка, ставати на ніжки, а в 10 - 11 місяців починає
ходити.
Швидко розвивається нервова система
і психіка. Вища нервова діяльність дитини грудного віку перебуває в стадії
диференціювання і вдосконалення, хоч функціонально переважає перша сигнальна
система. Починає формуватись друга сигнальна система - мова, виробляються
численні умовні рефлекси.
Раннє дитинство (ясельний період)
характеризується тим, що дитина починає самостійно ходити, бігати, швидко
костеніє скелет, харчується тією самою їжею, що й дорослі. До двох років у
дитини з’являються всі 20 молочних зубів. Збільшується головний мозок,
інтенсивно розвивається мова. Тривалість фізіологічного сну поступово
зменшується, функція захисного опору і адаптації до мінливих умов середовища,
зокрема функція теплорегуляції, продовжує розвиватись.
У дошкільному періоді (перше
дитинство) дуже швидко відбувається психічний розвиток дитини за рахунок
моторики. Триває процес окостеніння скелета. В кінці періоду починається зміна
молочних зубів на постійні. Продовжують розвиватись коркові і підкоркові центри
головного мозку, закінчується формування чіткої мови. У цьому віці формуються
риси характеру. До 7 років закінчується диференціювання структури кори
головного мозку, а також інтенсивне наростання маси головного мозку. Гальмівний
контроль кори головного мозку над інтенсивними реакціями підкори починає
розвиватись помітніше, ніж у дошкільному віці.
Шкільний період - вирішальний період
у фізичному, розумовому і духовному розвитку людини.
Молодшому шкільному періоду (друге
дитинство) характерно уповільнення темпів росту (4 - 5 см на рік). У 7 років
стійкішими стають шийний і грудний вигини хребта, міцніє скелет дитини,
розвиваються і сильнішають м’язи, особливо дрібні. Продовжує розвиватись
функція дихання, збільшується життєва ємність легень, розвивається
диференціювання кольорів і правильне сприйняття форми, підвищується здатність
розрізняти тони і висоту звуку. У цей період діти починають навчатися,
оволодіваючи грамотою, читанням, математикою. Малювання, ліплення, писання,
в’язання сприймають розвиткові дрібних м’язів кисті. У процесі навчання
спостерігається розвиток розумових здібностей учнів.
Середній шкільний вік (підлітковий)
- це період статевого дозрівання, в якому відбуваються зміни в діяльності
ендокринних залоз, особливо статевих. Значно посилюється процес окостеніння
скелета, спостерігається збільшення м’язової сили. Маса головного мозку
збільшується мало, однак дуже ускладнюється структура нервових клітин кори
головного мозку. Кровоносні судини розвиваються повільніше, ніж серце, тому
просвіт артерій на одиницю маси зменшується. Це може спричинити тимчасовий
розлад кровообігу, внаслідок чого спостерігаються запаморочення, тимчасові
підвищення кров’яного тиску, порушення роботи серця. Такі зміни діяльності
серцево - судинної системи з віком минають, але саме в підлітковий період їх
потрібно враховувати в режимі праці та відпочинку.
У старшому шкільному віці (юнацький
період) ще триває окостеніння в різних частинах скелета, але непропорційність у
розвитку кісток скелета кінцівок і тулуба зникає. Зміцнюється м’язова система,
підвищується м’язовой тонус, рухова активність і працездатність організму. Цей
період збігається з періодом статевого дозрівання, яке супроводжується змінами
діяльності залоз внутрішньої секреції. У 17 - 18 років школяр за розвитком
м’язової системи наближається до остаточно сформованого типу дорослої людини.
Період статевої зрілості у жінок настає після 20 років, у чоловіків після 22 -
24 років [27].
Розділ 2. Матеріали та методи
дослідження
Матеріалом для дослідження служила
кров дітей різних вікових періодів, взята у дітей обох статей у віці від 1 дня
до 21 року. Взяття матеріалу здійснювали в клініко-діагностичній лабораторії
при Миколаївській міській дитячій лікарні №2.
Для вивчення мазків крові
використали матеріал, що забирали від осіб, які проходили обстеження у
Миколаївській дитячій лікарні №2.
Після взяття матеріал фіксували на
предметному склі і досліджували за допомогою світлового мікроскопу Primo Star.
Мікрофотографування здійснювали за допомогою цифрової фотокамери «Canon», яка
була вмонтована у мікроскоп за допомогою фотонасадки. Макрофотографування
здійснювали шляхом послідовного переміщення мікропрепарату під об’єктивом
мікроскопу по декільком рядам.
Підрахування абсолютної кількості
лейкоцитів здійснювали аналізатором Medonic М-серія, а підрахування
лейкоцитарної формули - на 11 - клавішному лічильнику СЛФ - ЭЦ - 01 - 09.
.1 Техніка забору крові
Для більшості досліджень
використовується капілярна, венозна або артеріальна кров.
Повне голодування не є абсолютно
необхідним при проведенні більшості гематологічних досліджень, а легкий
нежирний сніданок суттєво не впливає на показники крові.
При дослідженні капілярної крові
роблять прокол м’якоті IV пальця лівої руки (у новонароджених та немовлят -
прокол мочки вуха) стерильною одноразовою голкою - скарифікатором. Шкіру пальця
дезинфікують стерильним тампоном, змоченим 70˚-ним спиртом, а потім
знежирюють ефіром. Прокол роблять на глибину 3 - 4 мм, палець краще проколювати
на боковій поверхні, де густіше сіть капілярів. Перша крапля знімається
стерильним ватним тампоном, друга крапля наноситься на предметне стекло і з неї
готується мазок крові. Наступні краплі набирають стерильним капіляром
Панченкова на предметне стекло, причому до кінця забору крові краплі повинні
витікати вільно, без натискання та масажу пальця, в протилежному випадку до
крові буде примішуватись тканинна рідина, що викривляє результати аналізу.
Венозна кров забирається в необхідному об’ємі з ліктьової вени після накладання
джгута. Забір крові не слід проводити після фізичного навантаження, в період
менструації. Як правило, забір крові призводиться у 8 год. Ранку через 30
хвилин після сну. При дослідженні показників крові в динаміці забір крові
бажано призводити в один і той же час.
Для підрахування кількості
еритроцитів, лейкоцитів, тромбоцитів та визначення вмісту гемоглобіну в пробу
беруть 20 мл крові. Для підготування мазків крові необхідно на предметне стекло
з краплею крові приставити шліфоване стекло під кутом 45˚ та, почекавши
доки кров розпливеться вздовж ребра шліфованого стекла, швидким рухом без
натиснення рухати шліфоване стекло до тих пір, доки крапля не буде вичерпана.
Готують не менш двох мазків. Правильно виготовлений мазок має жовтуватий колір,
не досягає країв стекла та закінчується «метелкою». Отримані мазки сушать, по
центру простим олівцем пишуть прізвище хворого, потім їх фіксують та фарбують
[24].
.2 Фіксація препаратів крові
Фіксація - засіб впливу на клітинну
структуру для максимального збереження морфологічної будови та хімічних
властивостей клітини. Механізм дії фіксаторів заснований на тому, що фіксуючі
рідини надають форменним елементам крові стійкість по відношенню до води, що
міститься у фарбах, яка без фіксації мазків лізує еритроцити та змінює будову
лейкоцитів. Крім того, фіксація викликає коагуляцію клітинних білків та
стабілізацію ліпідів, прикріплює клітини до скла, підвищує спорідненість до
фарбників, попереджує посмертні зміни в клітинах (аутоліз). На якість фіксації
впливає ряд чинників: рН середовища, ізотонічність розчину, температура,
тривалість фіксації. Для більшості фіксаторів рН дорівнює 7,2. При зміщенні рН
в кислий або лужний бік змінюється спорідненість структурних елементів клітин
до фарбників. З метою нейтралізації рН використовуються буферні суміші. При
порушенні ізотонічності змінюється об’єм клітини, ядерно - цитоплазматичне
співвідношення, структура хроматину тощо.
Температурний фактор впливає на
тривалість фіксації. При підвищенні температури час фіксації скорочується, при
зниженні - продовжується. При виконанні термінових цитологічних досліджень
допускається короткочасне підвищення температури при фіксації, але при цьому
якість препаратів знижується.
Тривалість фіксації залежить від
виду фіксуючих рідин. Необхідно пам’ятати, що корегувати неправильну фіксацію
препаратів не можливо. Критерієм оцінки якості фіксації є: стійке утримання
препарату на поверхні предметного стекла при використанні проміжної промивки,
відсутність гемолізу, зберігання в клітині певних біологічно активних речовин.
За складом фіксатори розподіляються
на прості та складні. До простих фіксаторів відносяться: хімічно чистий
метиловий спирт (метанол), етиловий 96˚ спирт, денатурований спирт, пари
формаліну, пари фенолу. До складних фіксаторів відносяться: суміш Никифорова,
етиловий спирт з попередньою обробкою 15%-вим водним розчином сірчанокислого
цинку, розчин сірчанокислого цинку, виготовлений на ізотонічному розчині
хлориду натрію, фіксатор - барвник Мея - Грюнвальда.
При фіксації метиловим спиртом мазки
витримують не менше 5 хв.; в етиловому, денатурованому спирті - не менше 30 хв.
Іноді для підвищення якості фіксації
мазків етиловим спиртом за рахунок попередньої їх обробки цитратом та оксалатом
натрію (фіксація за Яхонтовою) призводиться наступним чином:
Готують два реактиви:
Реактив №1 - в циліндр з об’ємом 100
мл вносять 1,5 г цитрату, приливають 1,5 мл дистильованої води, розмішують
скляною паличкою та для прискорення розчинення поміщають циліндр у водяну баню.
Утворюється мутнуватий розчин, до нього приливають етиловий спирт до об’єма 100
мл та на протязі 5 - 8 хв розмішують. При цьому на дні утворюється клейка біла
речовина, що тягнеться за паличкою. Розчин залишають на добу;
Реактив №2 готують аналогічним
чином, але замість цитрату беруть оксалат натрію.
Через добу прозорі реактиви №1 та №2
зливають в різних кількостях та в цій суміші фіксують мазки крові 20 - 30 с,
висушують та фарбують [25].
.3 Фарбування препаратів крові за
Романовським - Гімзою
На сухі нефіксовані мазки наливають
фарбник Романовського, що складається з однієї частини готового фарбника
Романовського та 3 частин етилового 90˚ спирта, на 1 - 1,5 хв. не зливаючи
фарбника, додають до нього таку ж кількість буферної води, слідкуючи за тим,
щоб вода при з’єднанні з фарбником не зливалась з мазку. Через 20 - 30 хв.
Фарбник змивають водою, мазок висушують [22].
.4 Підрахування лейкоцитарної
формули
Лейкоцитарна формула (лейкограма) -
це відсоткове співвідношення різних видів лейкоцитів в мазку крові.
Підрахування лейкограми слід
проводити в тонких ділянках мазку по верхньому та нижньому його краю,
переміщуючи мазок по лінії меандра. Рекомендується підраховувати клітини в
декількох ділянках мазку (по 25 клітин), сумарна кількість клітин не повинна
бути менша за 100. При наявності відхилень від норми необхідно підрахувати ще
100 клітин. Реєстрацію кількості клітин при підрахуванні лейкоформули
призводять за допомогою 11 - клавішного лічильника СЛФ - ЭЦ - 01 - 09.
Відсотковий вміст різних форм
лейкоцитів не відображує їх істинної кількості в 1 літрі крові, тому для оцінки
стану лейкограми крім загальної кількості лейкоцитів та відсоткового вмісту
окремих видів лейкоцитів слід враховувати абсолютний вміст останніх.
Визначити абсолютний вміст окремих
видів лейкоцитів в одиниці об’єму крові можна за формулою:
Х=(А×Б)/100; де
А - вміст певного виду лейкоцитів
(%);
Б - загальна кількість лейкоцитів (Г×л-1) [25].
Для дослідження забиралася кров у
здорових дітей, які проходили обстеження в дитячій лікарні №2. Всього вивчено
показники лейкоцитів у 35 дітей основних вікових груп. Для аналізу і
зіставлення використовувалися середні показники.
.5 Підрахування кількості лейкоцитів
При підрахуванні кількості
лейкоцитів в камері Горяєва кров, що досліджують, розводять в 20 разів. Для
цього в аглютинаційну пробірку наливають 0,4 мл 3%-вого розчину оцтової
кислоти, підфарбованого метиленовим синім та 20 мкл крові. Кінчик піпетки слід
витерти фільтрувальною бумагою. Кров видувають на дно пробірки, перемішують.
Лічильну камеру Горяєва готують
наступним чином: ретельно знежирюють, витирають насухо та притирають покривне
скло до камери до появи по краях райдужних кілець, що свідчить про те, що
висота камери дорівнює 0,1 мм. Розведеною та ретельно перемішаною кров’ю
заповнюють лічильну камеру, слідкуючи за тим, щоб кров рівномірно, без пухирців
повітря заповнила усю поверхню сітки, не затікаючи в борозди.
Підрахування кількості лейкоцитів
здійснюють через 1-2 хв в камері Горяєва в 100 великих квадратах, що не
розкреслені. Розрахунок кількості лейкоцитів призводять за формулою:
Х=(В×250×20)/100=В×50; де
В/100 - середнє число лейкоцитів в 1
великому квадраті;
- розведення крові;
- множник, що призводить результат
до об’єму 1 мкл [25].
Розділ 3. Результати власних
досліджень та їх обговорення
В результаті власних досліджень виявлено,
що абсолютний вміст лейкоцитів в крові дітей різних вікових періодів постійно
зменшується від народження до 21 року (Див. рис.3.1).
Досліджуючи абсолютний вміст
лейкоцитів в крові можна зробити висновок: в перший віковий період за А. А.
Маркосяном (період новонародженості) абсолютний вміст лейкоцитів в крові
найвищий і становить 12,7×109/л. У наступному періоді - грудному - абсолютний вміст
лейкоцитів знижується до 9,1×109/л. Динаміка поступового зниження абсолютних показників
лейкоцитів продовжується до 6 періоду і становить 6,8×109/л і лише в кінці
підліткового віку і весь період юнацького віку абсолютний вміст лейкоцитів
підвищується і дорівнює нормі дорослої людини.

Рис.3.1 Абсолютна
кількість лейкоцитів, (n×109/л)
Еозинофіли мають округлу
форму, їх розміри складають в діаметрі 12 - 15 мкм. Поліморфне ядро еозинофіла
займає більшу частину клітини і зазвичай складається із двох, рідше трьох -
чотирьох широких та округлих сегментів.цитоплазма клітини містить велику
кількість великих і майже однакових за величиною, але неоднорідних по формі
зерен (гранул) - округлих, овальних чи видовжених. Фарбуються еозинофіли, за
Романовським - Гімзою, в оранжево-червоний колір. На рис.3.3 зображено
мікрофото еозинофіла.
Рис.3.3 Морфологія
еозинофіла
Розглянувши графіки
відсоткового і абсолютного вмісту еозинофілів в формулі крові з отриманими
показниками в результаті досліджень спостерігається наступна динаміка: в період
новонародженості (за А. А. Маркосяном) і відсоткові, і абсолютні показники
найвищі і складають в першому графіку (рис.3.2) 3,4%, в другому (рис.3.4) -
0,43×109/л. Починаючи з грудного періоду показники обох графіків
знижуються до першого дитинства, а вже з п’ятого періоду (друге дитинство)
відсоткові і абсолютні показники зростають включно до юнацького віку і
складають 3% (рис.3.2) і і 0,2×109/л (рис.3.4).

Рис.3.2 Відсотковий
вміст еозинофілів в формулі крові, (%)

Рис.3.4 Абсолютна
кількість еозинофілів, (n×109/л)
Рис.3.6 Морфологія
базофіла
Розглянувши графіки
відсоткового і абсолютного вмісту базофілів в формулі крові з отриманими
показниками в результаті досліджень спостерігається наступна динаміка: в період
новонародженості (за А. А. Маркосяном) і відсоткові, і абсолютні показники
найвищі і складають в першому графіку (рис.3.5) 0,6%, в другому (рис.3.7) -
0,076×109/л. У грудному періоді спостерігається зниження обох
показників, а в третьому періоді - показники дещо підвищуються. У першому та
другому дитинствах показники знову знижуються: відсоткові показники у цих
періодах однакові - 0,4%, а абсолютні дещо відрізняються - у четвертому 0,03×109/л,
і 0,028×109/л у п’ятому. У останніх двох періодах (шостий і сьомий) і
відсоткові, і абсолютні показники знову підвищуються і становлять: відсотковий
вміст підліткового та юнацького років однакові і дорівнюють 0,6%, а абсолютні
показники базофілів становлять 0,04×109/л
у шостому періоді і 0,041×109/л - у сьомому.

Рис.3.5 Відсотковий
вміст базофілів в формулі крові, (%)

Рис.3.7 Абсолютна
кількість базофілів, (n×109/л)
Паличкоядерний нейтрофіл
має розміри 10 - 16 мкм. В цитоплазмі цих лейкоцитів, яка займає більшу частину
клітини, розташоване ядро, яке має форму палочки, букви S, підкови і т.д.
Мікрофото палочкоядерного нейтрофіла у третьому віковому періоді зображено на
мал.3.9.
Рис.3.9 Морфологія
паличкоядерного нейтрофіла
Аналізуючи відсоткові і
абсолютні показники паличкоядерних в формулі крові можна сказати наступне: як і
в інших графіках відсоткові і абсолютні показники найвищі у період
новонародженості. Далі аналізуючи відсоткові показники паличкоядерних можна
сказати, що суттєвих змін в їх кількості в різних вікових періодах не
спостерігаєтьсяі вони становлять 2%, крім четвертого періоду (перше дитинство),
в якому показник підвищується до 2,2×109/л.
Це може бути пов’язано з тим, що в цей період відбувається другий перехрест
нейтрофілів і лімфоцитів.
Розглядаючи абсолютну
кількість паличкоядерних нейтрофілів можна помітити, що починаючи другого
періоду (грудного) відбувається поступове зниження показників аж до останнього
періоду (юнацького).

Рис.3.8 Відсотковий
вміст паличкоядерних в формулі крові, (%)

Рис.3.10 Абсолютна
кількість паличкоядерних, (n×109/л)
Сегментоядерний
нейтрофіл - діаметр 10 - 15 мкм. Ядро темно - фіолетового кольору, займає
центральне положення, складається із 2 - 5 сегментів. Окремі частини ядра
з’єднані тонкими перетяжками. Ядерний хроматин нерівномірний. Цитоплазма
оксифільна, заповнена великою кількістю пилеподібних нейтрофільних гранул.
Мікрофото сегментоядерного нейтрофіла зображено на рис.3.11.
Рис.3.11 Морфологія
сегментоядерного нейтрофіла
Розглянувши графіки
відсоткового вмісту і абсолютної кількісті сегментоядерних нейтрофілів в
формулі крові спостерігається, що в першому періоді (новонародженості) їхній
вміст підвищений і становить 48,4% та 6,1×109/л.
У грудному періоді показники обох графіків найнижчі і дорівнюють 30,4% ті 2,7×109/л.
Починаючи з періоду раннього дитинства спостерігається динаміка поступового
збільшення відсоткових і абсолютних показників. В останньому періоді вони
найвищі і становлять 70,4% і 4,8×109/л.

Мал.3.12 Відсотковий
вміст сегментоядерних в формулі крові, (%)

Мал.3.13 Абсолютна
кількість сегментоядерних, (n×109/л)
Розглянувши всі вище
вказані графіки було встановлено таку закономірність, що найвищі відсоткові і
абсолютні показники гранулоцитів у першому періоді - періоді новонародженості.
Це пов’язано з тим, що що імунітет новонародженого ще не сформований до кінця.
Дитина народжується стерильною і відразу ж оточується величезною кількістю
найрізноманітніших антигенів. Уроджений імунітет у нього недосконалий, шкіра і
слизові оболонки тонкі, і також не можуть захистити дитину від проникнення в
організм бактерій і вірусів. Придбаний клітинний імунітет ще не працює на повну
потужність - адже він вперше стикається з різними антигенами, тому Т-лімфоцити
ще не навчилися розпізнавати ворогів, а кілери вбивати їх. Відповідальність за
боротьбу з чужорідними елементами, представленими вірусам і бактеріями, лежить
на білих тільцях крові - лейкоцитах. Лейкоцити можуть розрізняти типи
збудників, здатних привести до розвитку інфекції.
Підвищення відсоткової
та абсолютної кількості гранулоцитів у підлітковому віці можна пояснити тим, що
це період статевого дозрівання, в якому відбуваються зміни в діяльності
ендокринних залоз, особливо статевих.
Висновки
Гранулоцити - це
зернисті лейкоцити, білі кров'яні клітини, що містять в цитоплазмі специфічну
зернистість. По здатності зерен забарвлюватися гранулоцити поділяють на
еозинофіли, базофіли і нейтрофіли. У крові людини гранулоцити складають основну
масу лейкоцитів. Відсоткове співвідношення між окремими видами гранулоцитів
змінюється з віком, фізіологічним станом і при захворюваннях.
Еозинофіли мають округлу
форму, їх розміри перевищують розміри нейтрофілів і складають в діаметрі 12-15
мкм. Поліморфне ядро еозинофіла займає більшу частину клітини і зазвичай
складається із двох, рідше трьох-чотирьох широких та округлих сегментів,
з’єднаних перемичкою. Цитоплазма клітини містить велику кількість великих і
майже однакових за величиною, але неоднорідних по формі зерен (гранул) -
округлих, овальних або видовжених.
Головні функції
еозинофілів - клітин імунної системи - полягають в участі в механізмах захисту
при гельмінтозах, паразитозах і в реакціях гіперчутливості повільного типу,
пов’язаних з гострою алергією. В знищенні антигенів (паразитів, алергенів)
приймають участь різноманітні фактори, включаючи гістамін базофілів тучних
клітин. Еозинофіли контролюють надлишкове виділення гістаміну і нейтралізують
його.
Базофільні гранулоцити
представляють собою клітини округлої форми. Їх розміри складають 8 - 10 мкм.
Цитоплазма при фарбуванні набуває рожево-фіолетового кольору, вона оксифільна,
тобто фарбується кислими барвниками, що обумовлено кислими властивостями
структур, які фарбуються. В цитоплазмі міститься велика кількість гранул, які
фарбуються базофільними (основними) барвниками в темно - фіолетовий колір.
Функції базофілів пов’язують з їх участю в алергічних і запальних реакціях за
рахунок вмісту в них біологічно активних речовин, зокрема, гістаміну та
гепарину.
Нейтрофільні гранулоцити
представляють собою найбільшу групу циркулюючх лейкоцитів. Середній діаметр
нейтрофіла 9 - 15 мкм. Зрілий нейтрофіл характеризується помірно компактним
ядром паличкоподібної або полісегментованої форми; при полісегментації ядра
зазвичай є 2 - 4 сегменти, з’єднаних перетяжками ядерної речовини. Цитоплазма
фарбується в рожевий колір, наповнена дрібною (пилеподібною) зернистістю, яка
слабо сприймає азур та еозин, тобто нейтральною.
Нейтрофіли, яких ще
називають макрофагами, є головними ефекторними клітинами при гострому
запаленні, першою лінією захисту, і їх основні функції заключаються у
фагоцитозі - захопленні і перетравленні чужорідного матеріалу (мікробних
агентів, грибів та інших частин) та секреції цитокінів.
Проаналізувавши
результати, які було встановлено в результаті дослідження, було встановлено
таку закономірність, що найвищі відсоткові і абсолютні показники гранулоцитів у
першому періоді - періоді новонародженості. Це пов’язано з тим, що що імунітет
новонародженого ще не сформований до кінця. Дитина народжується стерильною і
відразу ж оточується величезною кількістю найрізноманітніших антигенів.
Уроджений імунітет у нього недосконалий, шкіра і слизові оболонки тонкі, і
також не можуть захистити дитину від проникнення в організм бактерій і вірусів.
Придбаний клітинний імунітет ще не працює на повну потужність - адже він вперше
стикається з різними антигенами, тому Т-лімфоцити ще не навчилися розпізнавати
ворогів, а кілери вбивати їх.
Підвищення відсоткової
та абсолютної кількості гранулоцитів у підлітковому віці можна пояснити тим, що
це період статевого дозрівання, в якому відбуваються зміни в діяльності
ендокринних залоз, особливо статевих.